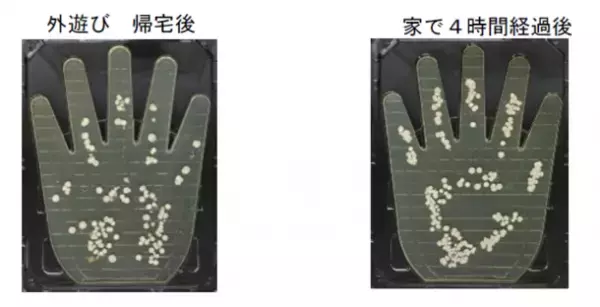
“家の中”で4時間過ごすだけで、手の菌量は“屋外”で2時間遊んだ後に匹敵！自宅内で知らないうちに手に付着する菌の増殖を石けん成分配合のハンドソープによる手洗いで抑制！

“家の中”で4時間過ごすだけで、手の菌量は“屋外”で2時間遊んだ後に匹敵!自宅内で知らないうちに手に付着する菌の増殖を石けん成分配合のハンドソープによる手洗いで抑制!
ライオン株式会社(代表取締役社長・掬川 正純)は、コロナ禍で手洗い意識が高まっていても、自宅にいる場合は、食事の前などにハンドソープで手を洗う人が少ない(※1)ことがわかったことを受け、自宅で過ごす時と屋外で遊んだ後の手の菌量を調べました。その結果、自宅で4時間過ごした後の手の菌量は、公園の遊具で2時間遊んだ後の手の菌量と同程度であることがわかりました。さらに、手洗い後の抗菌・抗ウイルス効果の持続性について、水での手洗いとハンドソープによる手洗いを評価したところ、石けん成分を配合したハンドソープの持続性が高く、菌やウイルスの増殖を抑制することがわかりました
「手洗い」は感染予防のポイントの一つです(※2)。一日中、家の中で過ごしている場合は、手洗いを行う場合も水洗いで簡単にすませがちですが、感染予防のためには、食事前やトイレ後等に、しっかりハンドソープで手を洗うことが大切です。
(※1) 2021年10月6日発表済「コロナ禍での手洗い実態調査」
https://lion-corp.s3.amazonaws.com/uploads/tmg_block_page_image/file/7726/20211006.pdf
(※2) 厚生労働省ウェブサイト
https://www.mhlw.go.jp/stf/seisakunitsuite/bunya/0000121431_00094.html

手のひらの菌の様子
【サマリー】
1. 家に居るだけでも4時間経つと、公園遊びをした後の手の菌量と変わらない結果に
2. 石けん成分配合のハンドソープで手を洗うと、手の抗菌・抗ウイルス効果が持続する
■実験結果
1. 家の中で4時間過ごすだけで、公園の遊具で遊んだ後の手の菌量と変わらない結果に!?
当社が2021年に実施した「コロナ禍での手洗い実態調査」(※1)によると「外出先から戻った際は、必ずハンドソープで手を洗う」と回答した人が約7割であるのに対し、自宅にいる場合は「食事前にハンドソープを使って手を洗う」人が4割未満と手を洗わない人が多いという結果でした。自宅で手を洗わない理由を聞くと「家の中はきれいだから」「家の中だから大丈夫という変な安心感がある」など、家の中にいる安心感から、ハンドソープで手を洗おうという意識が低下していたことがわかりました。そこで、家の中で過ごしていれば、手が菌などで汚れにくいのかを調べるため、「(1)帰宅直後に手を洗ってから自宅に4時間いた際((1)自宅)」と「(2)公園の遊具で2時間遊んだ後に帰宅((2)公園)」の“手のひらの菌の付着量”を比較しました。その結果、「(1)自宅」「(2)公園」の菌の付着量は同程度であることがわかりました(図1)。
https://www.atpress.ne.jp/releases/328742/img_328742_2.png
図1 手のひらの菌付着量の比較
<実験方法 (手のひらの菌付着量比較実験)>
下記のそれぞれの条件で過ごしたのち、「寒天培地(X-GAL 寒天培地、日水製薬株式会社製)」に手のひらを押し当て、その後30℃で24時間培養して比較(n=3)。
(1)手を洗ってから自宅で4時間経過後
市販のハンドソープで手洗いした後、4時間自宅におり、テレビを観たり、おやつを食べたりして過ごす
(2)公園の遊具で2時間遊んで帰宅後
2. 石けん配合のハンドソープで手を洗うと、手の菌の増殖を抑制!
手洗い後の抗菌・抗ウイルス効果の持続性を調べるために、市販のハンドソープに配合されている成分で手を洗った場合と、水道水のみで手を洗った場合で、手の菌・ウイルス量を評価しました。市販のハンドソープの成分は、(1)石けん系成分であるラウリン酸等の脂肪酸、(2)ポリオキシエチレンラウリルエーテル硫酸塩(POEラウリルエーテル硫酸塩)の2種で行いました。
結果、水道水で洗うよりも、ハンドソープ成分を使用した方が手洗い30分後の比較で、抗菌・抗ウイルス効果があることがわかりました。さらに、市販のハンドソープ成分の中でも、(1)石けん系成分である脂肪酸で手を洗った場合、1時間程度効果が持続することがわかりました(図2、図3)。
2021年7月に行った「コロナ禍での手洗い実態調査(※1)」によると、1日の平均手洗い回数は8.9回でした。手洗いするときは、できるだけ、ハンドソープで手を洗うことで、持続的な抗菌・抗ウイルス効果を得られる可能性が示唆されました。
https://www.atpress.ne.jp/releases/328742/img_328742_3.png図2 各種水溶液の抗菌持続性評価結果(n=2)
https://www.atpress.ne.jp/releases/328742/img_328742_4.png
図3 各種水溶液の抗ウイルス持続性評価結果(n=2)
<実験方法(手洗いの効果)>
・想定行動
1日の生活行動ヒアリングから、頻度が多い「ドアノブを握る行動」(24回/日:活動時間中)を想定行動として設定。水またはハンドソープで手を洗い、1時間当たり4回ドアノブを握ったときの、抗菌・抗ウイルス効果の持続性を評価した。
・方法
モデル皮膚を、各種水溶液(脂肪酸、界面活性剤、水道水)で洗浄後(30分、45分、60分)、菌液またはウイルス液を、20分毎に4回塗布後、モデル皮膚から菌とウイルスを洗い出し、洗い出し液の菌数および感染価を算出、抗菌効果、抗ウイルス効果を評価した。
なお、手洗いによる抗菌・抗ウイルス効果に関する研究結果は、2021年10月に行われた日本油化学会主催の第53回 洗浄に関するシンポジウムにて報告しています(※3)。
(※3) 日本油化学会主催 第53回 洗浄に関するシンポジウム
日時:2021年10月12日(火)~15日(金)、オンライン
演題:手洗いによる抗菌・抗ウイルス効果の持続性に関する研究
演者:土岐 梨彩子、堀内 惇平、浅野 ほたか、立川 将史、白江 航、
古賀 丈一朗、内藤 厚志
■対策:家に居るときでも、ハンドソープで手洗いを
家で過ごすだけでも、菌やウイルスが手に付着することがあります。また、せっかく手を洗っても、水洗いでは、感染対策としては不十分です。つい水洗いしがちなトイレ後や飲食前、また定期的にハンドソープで手洗いすることが大切です。
自分のため、家族のために、いつもの衛生行動を見直し、正しい手洗い行動を“今日から始める”ことが大切です。
当社グループは、「次世代ヘルスケアのリーディングカンパニーへ」を経営ビジョンに掲げ、「より良い習慣づくりで、人々の毎日に貢献する」ことを企業のパーパス(存在意義)として活動を行っています。本研究は、当社提供価値領域の1つである「インフェクションコントロール」の取り組みの一環で、衛生を中心とした生活習慣づくりにより、今後も生活者の皆さまとともに、清潔に暮らせる社会の実現に貢献してまいります。【くらしの衛生情報】
衛生に関する疑問や不安に応えるとともに、上手な手洗いやうがいのコツなどの暮らしに役立つ情報を発信しています。
https://www.lion.co.jp/ja/cleanliness/
https://www.atpress.ne.jp/releases/328742/img_328742_5.png
くらしの衛生情報サイト 2次元バーコード
詳細はこちら
プレスリリース提供元:@Press
「手洗い」は感染予防のポイントの一つです(※2)。一日中、家の中で過ごしている場合は、手洗いを行う場合も水洗いで簡単にすませがちですが、感染予防のためには、食事前やトイレ後等に、しっかりハンドソープで手を洗うことが大切です。
(※1) 2021年10月6日発表済「コロナ禍での手洗い実態調査」
https://lion-corp.s3.amazonaws.com/uploads/tmg_block_page_image/file/7726/20211006.pdf
(※2) 厚生労働省ウェブサイト
https://www.mhlw.go.jp/stf/seisakunitsuite/bunya/0000121431_00094.html
手のひらの菌の様子
【サマリー】
1. 家に居るだけでも4時間経つと、公園遊びをした後の手の菌量と変わらない結果に
2. 石けん成分配合のハンドソープで手を洗うと、手の抗菌・抗ウイルス効果が持続する
■実験結果
1. 家の中で4時間過ごすだけで、公園の遊具で遊んだ後の手の菌量と変わらない結果に!?
当社が2021年に実施した「コロナ禍での手洗い実態調査」(※1)によると「外出先から戻った際は、必ずハンドソープで手を洗う」と回答した人が約7割であるのに対し、自宅にいる場合は「食事前にハンドソープを使って手を洗う」人が4割未満と手を洗わない人が多いという結果でした。自宅で手を洗わない理由を聞くと「家の中はきれいだから」「家の中だから大丈夫という変な安心感がある」など、家の中にいる安心感から、ハンドソープで手を洗おうという意識が低下していたことがわかりました。そこで、家の中で過ごしていれば、手が菌などで汚れにくいのかを調べるため、「(1)帰宅直後に手を洗ってから自宅に4時間いた際((1)自宅)」と「(2)公園の遊具で2時間遊んだ後に帰宅((2)公園)」の“手のひらの菌の付着量”を比較しました。その結果、「(1)自宅」「(2)公園」の菌の付着量は同程度であることがわかりました(図1)。
家の中で過ごしていても、外出から帰った時と同程度の菌が手に付着してしまうと推察されます。
https://www.atpress.ne.jp/releases/328742/img_328742_2.png
図1 手のひらの菌付着量の比較
<実験方法 (手のひらの菌付着量比較実験)>
下記のそれぞれの条件で過ごしたのち、「寒天培地(X-GAL 寒天培地、日水製薬株式会社製)」に手のひらを押し当て、その後30℃で24時間培養して比較(n=3)。
(1)手を洗ってから自宅で4時間経過後
市販のハンドソープで手洗いした後、4時間自宅におり、テレビを観たり、おやつを食べたりして過ごす
(2)公園の遊具で2時間遊んで帰宅後
2. 石けん配合のハンドソープで手を洗うと、手の菌の増殖を抑制!
手洗い後の抗菌・抗ウイルス効果の持続性を調べるために、市販のハンドソープに配合されている成分で手を洗った場合と、水道水のみで手を洗った場合で、手の菌・ウイルス量を評価しました。市販のハンドソープの成分は、(1)石けん系成分であるラウリン酸等の脂肪酸、(2)ポリオキシエチレンラウリルエーテル硫酸塩(POEラウリルエーテル硫酸塩)の2種で行いました。
結果、水道水で洗うよりも、ハンドソープ成分を使用した方が手洗い30分後の比較で、抗菌・抗ウイルス効果があることがわかりました。さらに、市販のハンドソープ成分の中でも、(1)石けん系成分である脂肪酸で手を洗った場合、1時間程度効果が持続することがわかりました(図2、図3)。
2021年7月に行った「コロナ禍での手洗い実態調査(※1)」によると、1日の平均手洗い回数は8.9回でした。手洗いするときは、できるだけ、ハンドソープで手を洗うことで、持続的な抗菌・抗ウイルス効果を得られる可能性が示唆されました。
https://www.atpress.ne.jp/releases/328742/img_328742_3.png図2 各種水溶液の抗菌持続性評価結果(n=2)
https://www.atpress.ne.jp/releases/328742/img_328742_4.png
図3 各種水溶液の抗ウイルス持続性評価結果(n=2)
<実験方法(手洗いの効果)>
・想定行動
1日の生活行動ヒアリングから、頻度が多い「ドアノブを握る行動」(24回/日:活動時間中)を想定行動として設定。水またはハンドソープで手を洗い、1時間当たり4回ドアノブを握ったときの、抗菌・抗ウイルス効果の持続性を評価した。
・方法
モデル皮膚を、各種水溶液(脂肪酸、界面活性剤、水道水)で洗浄後(30分、45分、60分)、菌液またはウイルス液を、20分毎に4回塗布後、モデル皮膚から菌とウイルスを洗い出し、洗い出し液の菌数および感染価を算出、抗菌効果、抗ウイルス効果を評価した。
なお、手洗いによる抗菌・抗ウイルス効果に関する研究結果は、2021年10月に行われた日本油化学会主催の第53回 洗浄に関するシンポジウムにて報告しています(※3)。
(※3) 日本油化学会主催 第53回 洗浄に関するシンポジウム
日時:2021年10月12日(火)~15日(金)、オンライン
演題:手洗いによる抗菌・抗ウイルス効果の持続性に関する研究
演者:土岐 梨彩子、堀内 惇平、浅野 ほたか、立川 将史、白江 航、
古賀 丈一朗、内藤 厚志
■対策:家に居るときでも、ハンドソープで手洗いを
家で過ごすだけでも、菌やウイルスが手に付着することがあります。また、せっかく手を洗っても、水洗いでは、感染対策としては不十分です。つい水洗いしがちなトイレ後や飲食前、また定期的にハンドソープで手洗いすることが大切です。
自分のため、家族のために、いつもの衛生行動を見直し、正しい手洗い行動を“今日から始める”ことが大切です。
当社グループは、「次世代ヘルスケアのリーディングカンパニーへ」を経営ビジョンに掲げ、「より良い習慣づくりで、人々の毎日に貢献する」ことを企業のパーパス(存在意義)として活動を行っています。本研究は、当社提供価値領域の1つである「インフェクションコントロール」の取り組みの一環で、衛生を中心とした生活習慣づくりにより、今後も生活者の皆さまとともに、清潔に暮らせる社会の実現に貢献してまいります。【くらしの衛生情報】
衛生に関する疑問や不安に応えるとともに、上手な手洗いやうがいのコツなどの暮らしに役立つ情報を発信しています。
https://www.lion.co.jp/ja/cleanliness/
https://www.atpress.ne.jp/releases/328742/img_328742_5.png
くらしの衛生情報サイト 2次元バーコード
詳細はこちら
プレスリリース提供元:@Press






